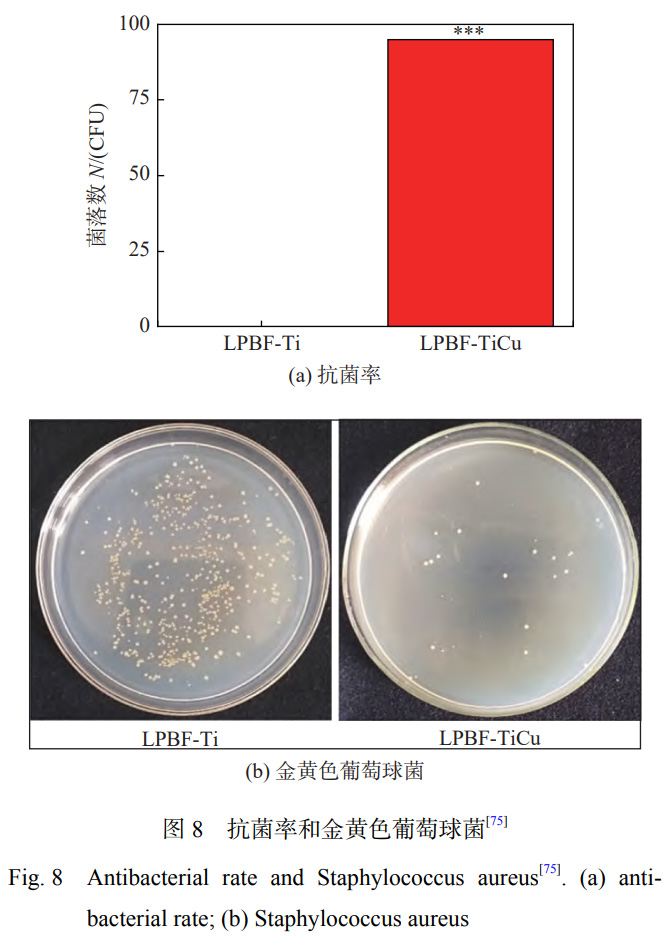

前言骨在人體內部主要起到支撐作用,是一種具有愈合和再生能力的硬組織[1]。由于骨的密度大、硬度高、破損后很難自然修復等特殊性,必須進行骨移植。鈦合金因具有輕質、彈性模量與人骨相近、耐腐蝕、生物相容性好等優點[2?3],被廣泛應用于工程機械、航空航天和生物醫學領域[4]。但是TC4基體對于金黃色葡萄球菌的抗菌率僅為14.5%[5],且鈦及鈦合金具有生物惰性,與骨骼機械結合的方式會導致摩擦產生碎屑,最終引發炎癥,從而導致植入手術失敗[6]。相對于在提高鈦合金種植體材料的骨結合、耐磨性和耐蝕性方面的研究,針對鈦合金骨科植入體細菌感染的研究仍處于早期階段[7]。
植入手術術后感染是植入失敗的主要原因之一,細菌引起的相關植入物感染風險從0.4%到16.1%不等[8]。引起細菌感染的重要原因是生物膜的形成[9]及由粘附的微生物聚集產生致密的胞外聚合物[10]。因此,防止或降低生物膜在植入過程中的形成具有重要作用。
目前,對于提高鈦及鈦合金植入材料抗菌性能的表面改性途徑包括涂覆抗生素、制備有機抗菌劑和無機抗菌劑涂層等技術來達到滅菌的作用[11]。研究發現,鈦合金表面制備依諾沙星涂層[12]、慶大霉素-HA涂層[13]、膦酸鹽/季銨鹽共聚物涂層[14]等有機抗菌劑涂層對鈦合金的抗菌性能都有較大程度的提高。但是,抗生素、有機抗菌劑的大量使用會導致細菌產生耐藥性且藥物作用時間較短[15]。無機抗菌劑主要包括Ag+,Cu2+,Zn2+,Co2+等,能夠在人體內穩定發揮作用且具有優良的抗菌性能和生物相容性。目前,在鈦合金中添加無機抗菌金屬元素的技術主要包括電弧熔煉、真空等離子燒結、離子注入、氣相沉積和激光表面改性技術等,將無機抗菌劑摻入合金體系或者表面,使植入材料獲得抗菌性能。其中,激光表面改性技術具有獨特的技術優勢,相對于電沉積、PVD/CVD技術,與基體材料具有較強的結合力。相對于熱噴涂技術,具有較小的熱影響區[16],對基材的影響較小。因此,激光表面改性技術具有廣闊的應用潛力。
激光表面改性技術既可以通過高溫熱源對表面進行重熔引發合金相轉變或構建表面紋理化來提高表面性能,又可以結合外源物質制備具有不同性能的表面涂層[17]。激光作為一種新型能源,具有局部選擇性、能量密度高、節省材料、凝固快、稀釋率低、熱影響區窄、冶金結合強度高等優點[18],也可以對合金的組織形態和析出相進行調控[19],被廣泛應用于材料加工領域。激光表面改性技術作為一種無機抗菌劑植入技術,在表面工程中具有廣泛的應用前景。
鈦及鈦合金作為主要的骨科植入材料,其抗菌性的研究成為重中之重,如何利用激光表面改性技術,改善植入物的抗菌性能成為現階段的研究熱點。文中綜述了激光表面改性技術的分類,以及采用激光表面改性技術對鈦及鈦合金進行表面合金化、表面織構和激光熔覆處理,研究激光表面改性方式對鈦合金抗菌性能的影響并對抗菌機理進行解釋。
1、激光表面改性技術
激光表面改性技術利用激光熱源與金屬或非金屬進行相互作用,通過添加相同或不同材料或對材料表面進行重熔來改善基體的表面性能,是一種清潔、安全、高效率的加工技術[20],是光學、冶金學、電子學、計算機學等為一體的高新技術,在現階段具有廣闊的應用前景。
激光表面改性技術主要包括表面硬化、激光重熔、織構化和激光熔覆等,分類如圖1所示。

激光表面處理技術在保護氣氛或者無保護氣條件下對材料進行表面加熱或重熔,可以對材料表面進行定向處理,其原理如圖2所示。激光表面處理包括激光重熔、激光合金化、激光紋理化和激光微納加工等技術。固體材料在受到激光束的作用下,有助于通過誘導微觀結構變化來進一步提高抗菌性能、表面硬度、耐磨性、耐腐蝕性等性能,從而實現表面改性[23]。同時,激光表面處理可應用于制備微納加工結構、改善金屬表面性能和加強固體材料粘結強度等方面。

激光熔覆技術是利用激光束的高能量密度,將基體材料熔化形成熔池,由保護氣體攜帶金屬粉末或絲材同時注入熔池,從而將其熔覆在受熱區域表面,形成具有冶金結合的功能性涂層,提高材料的表面性能,其原理如圖3[24]所示。激光熔覆技術是上世紀90年代以來快速發展的表面改性技術,現階段已經得到廣泛應用[18]。激光熔覆技術具有熱輸入能量集中、熱影響區小、變形小、基體能夠與熔覆層形成冶金結合、熔覆層稀釋率低等優點[25?26]。激光熔覆技術主要應用于提高基體耐磨性、耐蝕性、抗菌性和耐高溫性能等[27]。

2、激光表面處理鈦合金抗菌涂層
激光本質上是電磁波的一種,按照波長可分為紫外光、可見光和紅外光[28]。根據激光器功率的不同,選擇不同波長的激光對鈦及鈦合金進行處理。現階段,波長小于355nm的短波長激光可以對鈦及鈦合金進行切割;波長為532nm的綠光激光多用在醫療領域對鈦及鈦合金激光加工處理。激光表面處理技術主要通過改變鈦合金的表面化學成分和表面結構,對鈦合金植入物的抗菌性能進行調控。
在激光表面處理過程中,由于合金元素、表面結構和熔覆體系的不同,對激光表面處理鈦及鈦合金的結構和性能有不同程度的影響,從而達到不同的抗菌效果。
2.1 激光表面合金化
激光表面合金化技術(LSA)是利用激光熱源將基材熔化形成熔池,將高性能合金粉或氣體與基體發生反應形成一層新的合金化層,從而使材料具有高性能[29]。
通過激光表面合金化技術在合金表面添加適當含量的抗菌元素,可改變材料表面的合金成分。同時,由于激光能量可以熔化涂層和部分底層基體,激光表面合金化技術可以在合金層和基體之間形成牢固的冶金結合。QIAO等學者[30]使用波長較短(0.9μm)的高功率二極管激光器制備了TiNi與Ag的激光合金化涂層。研究表明:通過合金化技術可以使涂層中含有更多的Ti2Ni,β-Ti和Ag顆粒;在銀含量(質量分數)為4.6%時,涂層的硬度提高了109%;同時,合金化后涂層釋放的Ag+和Ag顆粒顯著提高了對大腸桿菌和金黃色葡萄球菌的抗菌效果。
在激光處理過程中,保護氣體不僅可以降低空氣中氧氣和水分等對激光表面處理的干擾和污染,提高表面處理的質量和效率[31],還可以與基體發生反應,形成合金化涂層。由于氮和鈦在熱力學上存在有利的相互作用,形成的氮化層對鈦合金的硬度和摩擦學性能有很大的提高[32]。鈦的氮化物(TiN)、氧化物(TiO2)等[31]都具有本征抗菌性能。鄒潔等學者[33]在牙科鈷鉻合金表面制備一層2.5μm厚度的TiN涂層,之后對涂層進行耐腐蝕和抗菌性試驗,發現:TiN涂層對變形鏈球菌或黏性放線菌有很好的抗菌性能。
DONAGHY等學者[34]利用光纖激光技術在高純N2保護下對TNZT(Ti-35Nb-7Zr-6Ta)合金進行處理,研究激光氮化處理對合金表面形貌、粗糙度、潤濕角以及抗菌性能的影響。結果表明:激光氮化處理后XRD檢測到較強的TiN峰值強度,能夠顯著提高表面粗糙度至1180.2nm,潤濕角降低至27.1°,親水性和生物相容性進一步提高,其抗菌效果如圖4[34]所示,合金表面細菌覆蓋率降低至0.72%。

鈦及鈦合金相對于其他材料抗菌和耐腐蝕的主要優點是可以在表面生成一層TiO2陶瓷膜[35]。研究表明:鈦合金在正常溫度下暴露1年,所形成的TiO2氧化膜的厚度為6nm,且與基體結合性很差,在較低的剪切力作用下就會被破壞[7]。激光表面處理可以改變氧化膜的厚度和表面粗糙度,進而提高合金的性能。
FATHI-HAFSHEJANI等學者[36]在氧氣氛圍內對鈦合金進行激光表面改性處理,鈦合金基體表面形成物相和形貌可控的高純度TiO2涂層。由于晶體TiO2涂層產生的光催化活性,具有不同相(銳鈦礦、金紅石)和不同形態的TiO2涂層在增強骨整合和抗菌行為方面表現出優異的性能。PARMAR等學者[37]通過對TC4進行納秒激光和氧化處理。研究表明:納秒激光處理表面發生微坑形式的物理和化學變化,表面電荷發生變化,Ti的氧化物含量增加,氧化可以促進激光微織構對金黃色葡萄球菌的粘附和增殖能力的抑制。
鈦與空氣中的碳、氫等都有非常高的反應活性。CUNHA等學者[38]在空氣中對鈦進行激光表面處理,在進行XPS檢測時,發現其有較高的碳峰,原因是空氣中含有較多的含碳污染物[39]。氬氣作為一種常見的惰性保護氣體,其多用于激光焊接和激光熔覆過程中防止有益元素的燒損和合金化[40],在鈦及鈦合金表面激光處理用以提高抗菌性能中的應用較少。
2.2 激光表面織構
激光表面織構技術可以對鈦合金進行表面結構設計或者進行重熔處理,改善鈦及鈦合金的表面結構。現階段,通過激光表面織構技術可以在鈦及鈦合金表面制備微米和納米尺寸的結構或紋理結構,進而影響合金表面的氧化膜厚度和表面粗糙度,降低表面載流子數量、提高表面峰度,有效地減少細菌的黏附或滅活細菌[41]。
納米級表面特征有利于減少細菌黏附和生長。CHAN等學者[7]通過連續波光纖激光器發射波長為1064nm近紅外激光對商業純鈦(cp-Ti)和TC4進行激光表面處理誘導納米特征結構的產生,其處理后表面如圖5所示。激光處理表面由波紋和放射狀片層構成的玫瑰狀標記組成,2種鈦合金均表現出較強的抗菌性能。從表面疏水性、膜成分、厚度和粗糙度等方面對抗菌機理進行解釋:①研究發現,金黃色葡萄球菌是疏水性的,其水接觸角為72.2°[42],而經過激光處理的表面表現出更強的親水性,水接觸角降低到30°~45°,減少了細菌的接觸。②細菌與植入物表面接觸是在表面電荷與細菌的靜電相互作用下進行吸引,使細菌黏附在植入物表面,在氮氣環境中進行激光表面處理會增大表面膜層的厚度,減少表面載流子的數量[43]。同時,表面膜層中存在大量的缺陷和空位,會造成電荷的富集,減少與細菌的相互作用[7]。③激光表面織構會增加材料的表面粗糙度,相同的表面粗糙度具有不同的峰度(Rku)和偏度(Rsk)[44],激光處理的鈦合金表面具有更高的峰度和偏度,使表面有更多的“尖刺”,減少細菌黏附的原理與蟬翼的殺菌作用相似[45],通過細菌與材料的相互作用將其吸附在表面,導致細菌的破裂和裂解。

CUNHA等學者[38]采用Yb:KYW激光器、發射波長為1030nm、脈沖持續時間為500fs的激光,在鈦合金表面構建了激光誘導周期性表面紋理結構(LIPSS)和納米柱2種表面織構,其表面結構如圖6所示,其Ra值分別為0.3μm和0.5μm,潤濕角分別為12.6°和32.1°。對其進行細菌培養試驗,未經激光處理試樣表面細菌覆蓋率為25%,激光處理后試樣表面金黃色葡萄球菌的覆蓋率為7%,對于細菌的生長有較好的抑制作用。研究表明:金黃色葡萄球菌優先附著于1~4nm的鈦合金表面[46],在Ra為5~8μm的樣品上形成的生物膜比在拋光(Ra=30nm)或機加工(Ra=0.5μm)表面上更強烈[47]。細菌優先粘附在粗糙度較高的表面,但也粘附在形貌特征大于細菌尺寸(一般為1~2μm)的表面。因此,激光誘導周期性表面紋理結構可以通過改善鈦合金表面的潤濕角和粗糙度降低細菌的黏附和增殖。

綜上所述,激光表面處理后鈦及鈦合金表面結構對于減少細菌的黏附主要包括兩方面:一是通過構建具有特征尺寸小于細菌尺寸和具有非常致密的特征表面,減少細菌與表面的接觸面積,抑制細菌的定植或刺破細菌,達到減少細菌滯留的目的;二是通過增大表面的凹陷程度,細菌無法穿過凹陷與表面建立穩定的連接,導致細菌只能黏附在個別的尖端,防止生物膜的形成。
2.3 激光熔覆抗菌涂層
激光熔覆技術可以在鈦及鈦合金表面熔覆不同體系的成分,改善鈦合金的性能。現階段,激光熔覆技術用于提高鈦及鈦合金抗菌性能的熔覆體系主要包括生物醫用金屬材料(Ag,Cu,Nb,Zn,Ta等[48])、生物陶瓷(HA,TiO2等[49])。激光熔覆技術可以顯著提高鈦及鈦合金的抗菌性能,尤其是對金黃色葡萄球菌和大腸桿菌等常見的致病菌有較好的抑制作用[50]。
2.3.1 Ag抗菌涂層
Ag具有超強的抗菌性,被廣泛應用于廣譜殺菌材料。SHI等學者[51]通過對高真空電弧爐熔煉的TiAg合金進行抗菌性試驗,發現:合金的抗菌性是由于Ti2Ag和Ag+的共同作用,且沒有引起細胞毒性。CHEN等學者[52]制成的Ti-Ag合金在經過熱處理后,對金黃色葡萄球菌的抑制率高達99%。表明:Ag的加入可以使合金獲得較強且穩定的抗菌性能。
XUE等學者[53]通過激光熔覆技術在Ti-20Zr10Nb-4Ta表面激光熔覆Ag箔,研究Ag微粒對于鈦合金抗菌性和相容性的影響,試驗結果表明:當激光功率為50W和70W時,經過處理的表面對于大腸桿菌的抑菌率分別達到96.3%和98.2%,對于金黃色葡萄球菌的抑菌率均達到100%,且隨著激光功率的增加,表面形成了鈍化膜,粗糙度增大,具有良好的耐腐蝕性能和生物相容性。ZHANG等學者[54]將Ag和ZnO納米顆粒摻入羥基磷灰石納米粉體中,通過激光熔覆技術沉積在TC4表面,對激光熔覆涂層的抗菌性能和骨整合性能進行研究。研究發現:納米Ag和HA在熔覆層表面呈棒狀,涂層與基體結合良好,最大熔深達到460μm,涂層的最小潤濕角約為10.5°。激光熔覆可以將復合涂層緊密地固定在TC4基體上,抑制了Ag離子的釋放速率,緩解了高Ag濃度下的細胞毒性[55],涂層具有優異的細菌抗性、成骨和骨整合能力。MAHARUBIN等學者[56]通過激光加工凈成形工藝將混合均勻的cp-Ti粉和Ag粉采用同步送粉方式在cp-Ti基體上制備銀含量(質量分數)為0.5%~2.0%的Ti-Ag合金,通過EDS檢測發現:Ag均勻地分布在基體上。通過對不同Ag含量的試樣進行金黃色葡萄球菌和銅綠假單胞菌進行抗菌性試驗,抗菌效果隨Ag含量的增加而增強,當Ag含量達到1.5%時,抗菌率分別達到99.79%和99.96%,且在Ag含量較低時,可以在不損害生物活性的前提下最小化細菌感染的風險。

目前,關于Ag對微生物的抑制和殺傷途徑主要歸結為以下觀點[57],其抗菌原理如圖7[58]所示。Ag能夠抗菌的主要原因是能被菌類吸附,帶正電荷的Ag+能與帶負電荷的微生物之間產生靜電吸引,從而促使Ag+附著在細胞膜上[59],細菌的細胞膜在與Ag接觸幾分鐘后就會被完全破壞[60]。同時,Ag能夠與細菌的蛋白質相互結合,破壞蛋白質的結構,阻礙細菌的新陳代謝,從而失去活性[61]。Ag+濃度的提高會導致細胞氧化反應的增加,微生物細胞氧化應激的增加是Ag+引起毒性作用的標志。由于Ag能夠促進細胞產生ROS和自由基,因此Ag具有強大的抗菌、抗真菌和抗病毒活性[62]。但是,抗菌性能與銀含量不存在線性關系,銀含量過高時,并不會顯著提高鈦合金的抗菌性能,反而可能產生細胞毒性[63]。
2.3.2 Cu抗菌涂層
不同的金屬材料殺菌能力也有所不同,其大小排序為:Cu>Fe>Sn>Al>Zn>Co[64]。Cu具有促進成骨細胞分化,誘導血管生長的作用。同時,作為人體必需的微量元素,有預防骨質疏松的作用[65]。ZHANG等學者[66]通過采用等離子燒結技術制備的Ti-Cu合金對大腸桿菌和金黃色葡萄球菌的抑制率達到99%。有研究報道,只有Ti-Cu合金的Cu含量(質量分數)在5%及以上,合金才具有抗菌率>99%的抗菌性能[67],表1為合金中Cu含量不同表現出的抗菌性能[68-71]。

JI等學者[72]采用激光選區熔化技術制備的Ti-(3,5,7,10)Cu合金(質量分數,%),Ti2Cu相在晶界預先形核并阻止晶粒長大,能夠很好的起到細化晶粒的作用。同時,由于激光選區熔化快速凝固的特點,Ti的平均晶粒尺寸為7.4μm,遠小于常規鑄造Ti的晶粒尺寸,快速凝固導致表面收縮而產生的細小孔洞,增加了細菌與合金的接觸面積,抗菌效果明顯增加。合金具有較小的Cu2+釋放且有較高的抗菌率。Ti-Cu合金與細菌細胞膜的直接相互作用導致膜的滲透性增強,細菌允許Cu2+進入細胞內,引起接觸殺菌[73]。經過激光選區熔化形成的Ti-3Cu合金的抗菌率相對于相同成分的鑄造合金,抗菌率提高約70%。
HOU等學者[74]通過激光熔覆技術在TC4表面原位制備摻雜Cu顆粒的Ca-Si基涂層,研究表明:激光處理后原位生成了Ca2SiO4,CaTiO3和Cu2O,涂層表現出良好的耐磨性和潤濕性;當Cu含量達到15%時,復合涂層具有對大腸桿菌最高的抗菌活性。LIU等學者[75]利用激光粉末床熔合(LPBF)技術在純鈦基體上制備抗菌Ti-Cu合金(LPBF-TiCu),激光快速加熱和冷卻的優點相對于傳統方法制作的Ti-Cu合金,會使Ti合金形成較多的針狀馬氏體(α′-Ti),由于其具有較低的能量狀態,會減緩鈦合金的腐蝕[76]。Cu的加入改善了LPBF-TiCu合金中馬氏體相變時形狀應變的自適應性,減少了位錯在晶界的堆積。LPBFTiCu合金可以顯著促進細胞的增殖,合金表面上的細胞具有更多的偽足,生物相容性良好,對金黃色葡萄球菌的抑制率達到94.81%,抗菌效果如圖8所示。
目前,關于激光熔覆含Cu涂層多用于改變金屬的耐磨性和耐腐蝕性[77?78],對于采用激光熔覆方式引入Cu提高植入物抗菌性能的研究較少。現階段關于Cu2+的殺菌機理主要解釋為含銅的抗菌金屬材料在溶液或體液環境下溶出會釋放帶正電的Cu2+離子,而細菌的生物膜通常帶負電荷,二者之間會產生吸附作用,從而導致細胞膜上的電荷分布不均勻,細菌形態在不均勻的庫侖力作用下發生變形,細胞膜的滲透性改變,最終造成細菌壁和細菌膜的破裂,導致細胞質的溶出,從而殺死細菌[79]。
3、結束語
(1)激光表面改性誘導鈦合金產生抗菌涂層的調控機理尚不明確,以及如何提升抗菌涂層制造技術的精確性,促進抗菌性和生物相容性更加協調,是現階段鈦合金激光表面改性的研究重點。
(2)雖然Ag,Cu等抗菌元素的抗菌性已經得到驗證。但是,目前對于金屬離子的抗菌機制及細胞毒性機制的研究尚不明確。不論是通過構建含有抗菌元素的抗菌涂層還是合金化處理,都需要保證植入物的長期無害性。因此,可以在保證抗菌元素的最小添加量下,同時加入多種微量抗菌元素。
(3)對于鈦及鈦合金的發展,仍然需要對引發炎癥和細菌感染方面投入大量研究。鈦合金的植入要在保證對人體組織長期無害的前提下,構建穩定且多功能的復合涂層以滿足實際應用中的多種需求,是鈦及鈦合金在生物醫用領域中未來研究的主要方向。
參考文獻
[1]POU P, RIVEIRO A, DEL VAL J, et al. Laser surface texturing of titanium for bioengineering applications[J].Procedia Manufacturing, 2017, 13: 694 ? 701.
[2]DU PLOOY R, AKINLABI E T. Analysis of laser cladding of titanium alloy[J]. Materials Today: Proceedings, 2018, 5(9): 19594 ? 19603.
[3]孫壯, 王偉, 王成, 等. 鈦合金表面激光熔覆耐磨和自潤滑 涂層的研究進展 [J]. 材料保護, 2023, 56(1): 107 ? 120.
SUN Zhuang, WANG Wei, WANG Cheng, et al. Research progress of wear-resistant and self-lubrication coatings prepared on titanium alloy surface by laser cladding[J]. Material Protection, 2023, 56(1): 107 ? 120.
[4]LIU S Y, SHIN Y C. Additive manufacturing of Ti6Al4V alloy: A review[J]. Materials & Design, 2019, 164: 107552.
[5] 吳耀佳, 張懋達, 付永強, 等. 含 Ag 硬質涂層的結構及其 摩擦腐蝕與抗菌特性的研究進展 [J]. 表面技術, 2021, 50(1): 94 ? 106, 161.
WU Yaojia, ZHANG Maoda, FU Yongqiang, et al. Research progress in structure, tribocorrosion and antibacterial properties of Ag-containing hard coatings[J]. Surface Technology, 2021, 50(1): 94 ? 106, 161.
[6]APAZA-BEDOYA K, TARCE M, BENFATTI C A M, et al. Synergistic interactions between corrosion and wear at titanium-based dental implant connections: A scoping review[J]. Journal of Periodontal Research, 2017, 52(6): 946 ? 954.
[7]CHAN C W, CARSON L, SMITH G C, et al. Enhancing the antibacterial performance of orthopaedic implant materials by fibre laser surface engineering[J]. Applied Surface Science, 2017, 404: 67 ? 81.
[8]ZIMMERLI W. Clinical presentation and treatment of orthopaedic implant-associated infection[J]. Journal of Internal Medicine, 2014, 276(2): 111 ? 119.
[9]CAMPOCCIA D, MONTANARO L, ARCIOLA C R. The significance of infection related to orthopedic devices and issues of antibiotic resistance[J]. Biomaterials, 2006, 27(11): 2331 ? 2339.
[10]FLEMMING H C, VAN HULLEBUSCH E D, NEU T R. The biofilm matrix: multitasking in a shared space[J].Nature Reviews Microbiology, 2023, 21(2): 70 ? 86.
[11]范競一, 馬迅, 李偉, 等. 醫用鈦合金表面改性技術研究進 展 [J]. 功能材料, 2022, 53(7): 7027 ? 7039.
FAN Jingyi, MA Xun, LI Wei, et al. Research progress of surface modification technology of biomedical titanium alloy[J]. Journal of Functional Materials, 2022, 53(7): 7027 ? 7039.
[12]NIE Bin’en, LONG Teng, AO Haiyong, et al. Covalent immobilization of enoxacin onto titanium implant surfaces for inhibiting multiple bacterial species infection and in vivo methicillin-resistant staphylococcus aureus infection prophylaxis[J]. Antimicrobial Agents and Chemotherapy, 2016, 60(1): e01766 ? 16.
[13]ALT V, BITSCHNAU A, ?STERLING J, et al. The effects of combined gentamicin-hydroxyapatite coating for cementless joint prostheses on the reduction of infection rates in a rabbit infection prophylaxis model[J].Biomaterials, 2006, 27: 4627 ? 4634.
[14]DONG Yaning, LIU Li, SUN Jin, et al. Phosphonate/quaternary ammonium copolymers as high-efficiency antibacterial coating for metallic substrates[J]. Journal of Materials Chemistry B, 2021, 9(39): 8321 ? 8329.
[15] 秦思民. 基于生物被膜的耐藥性抗菌劑研究和工程新材 料探索 [D]. 北京: 中國科學院大學, 2022.
QIN Simin. Research on drug-resistant antibacterial agents and exploration of new engineering materials based on biofilms[D]. Beijing, China: University of Chinese Academy of Sciences, 2022.
[16]王東生, 田宗軍, 沈理達, 等. 激光熔覆技術研究現狀及其 發展 [J]. 應用激光, 2012, 32(6): 538 ? 544.
WANG Dongsheng, TIAN Zongjun, SHEN Lida, et al. Research status and development of laser cladding technology[J]. Applied Laser, 2012, 32(6): 538 ? 544.
[17]崔振鐸, 朱家民, 姜輝, 等. Ti 及鈦合金表面改性在生物醫 用領域的研究進展 [J]. 金屬學報, 2022, 58(7): 837 ? 856.
CUI Zhenduo, ZHU Jiamin, JIANG Hui, et al. Research progress of the surface modification of titanium and titanium alloys for biomedical application[J]. Acta Metallurgica Sinica, 2022, 58(7): 837 ? 856.
[18]SIDDIQUI A A, DUBEY A K. Recent trends in laser cladding and surface alloying[J]. Optics & Laser Technology, 2021, 134: 106619.
[19]JU Jiang, ZAN Rui, SHEN Zhao, et al. Remarkable bioactivity, bio-tribological, antibacterial, and anti-corrosion properties in a Ti6Al4V-xCu alloy by laser powder bed fusion for superior biomedical implant applications[J].Chemical Engineering Journal, 2023, 471: 144656.
[20]張永康, 周建忠, 葉會霞, 等. 激光加工技術 [M]. 北京: 化 學工業出版社, 2006.
ZHANG Yongkang, ZHOU Jianzhong, YE Huixia, et al. Laser processing technology [M]. Beijing, China: Chemical Industry Press, 2006.
[21]SYPNIEWSKA J, SZKODO M. Influence of laser modification on the surface character of biomaterials: Titanium and its alloys-A review[J]. Coatings, 2022, 12: 1371.
[22]LIU Zhifang, NIU Tong, LEI Yaxi, et al. Metal surface wettability modification by nanosecond laser surface texturing: A review[J]. Biosurface and Biotribology, 2022(2): 95 ? 120.
[23]XU Yong, LIU Wei, ZHANG Gangqiang, et al. Friction stability and cellular behaviors on laser textured Ti6Al4V alloy implants with bioinspired micro-overlapping structures[J]. Journal of the Mechanical Behavior of Biomedical Materials, 2020, 109: 103823.
[24] WANG Xinlin, LEI Lei, YU Han. A review on microstructural features and mechanical properties of wheels/rails cladded by laser cladding[J]. Micromachines, 2021, 12(2): 152.
[25] ZHANG Yifu, ZHANG Hua, ZHU Zhengqiang, et al.Microstructure, properties and first principles calculation of titanium alloy/steel by Nd: YAG laser self-fluxing welding[J]. China Welding, 2018, 27(3): 1 ? 10.
[26]周佳良, 舒鳳遠, 趙洪運, 等. 激光熔覆在 AlN 陶瓷表面制 備銅基金屬覆層缺陷分析及控制 [J]. 焊接學報, 2019, 40(11): 133 ? 138.
ZHOU Jialiang, SHU Fengyuan, ZHAO Hongyun, et al. Analysis and control of defects in preparing copper-based metal coatings on AlN ceramic surface by laser cladding[J].Transactions of the China Welding Institution, 2019, 40(11): 133 ? 138.
[27]袁慶龍, 馮旭東, 曹晶晶, 等. 激光熔覆技術研究進展 [J].材料導報, 2010, 24(3): 112 ? 116.
YUAN Qinglong, FENG Xudong, CAO Jingjing, et al. Research progress of laser cladding technology[J]. Materials Reports, 2010, 24(3): 112 ? 116.
[28]王垚. 噴射電沉積前處理的激光表面處理方法與試驗研 究 [D]. 南京: 南京航空航天大學, 2019.
WANG Yao. Experimental Study on Laser surface treatment method of pre-electrodeposition[D]. Nanjing, China: Nanjing University of Aeronautics and Astronautics, 2019.
[29]林基輝, 劉德鑫, 李耀, 等. 激光合金化技術在表面改性中 的應用研究進展 [J]. 熱加工工藝, 2020, 49(8): 13 ? 16.
LIN Jihui, LIU Dexin, LI Yao, et al. Research Progress in application of laser alloying technology in surface modification[J]. Hot Working Technology, 2020, 49(8): 13 ? 16.
[30]QIAO Q, CRISTINO V A M, TAM L M, et al. Characterization of laser surface-alloyed Ti-Ni-Ag coatings and evaluation of their corrosion and antibacterial performance[J]. Surface and Coatings Technology, 2023, 474: 130119.
[31]CHAN C W, LEE S, SMITH G, et al. Enhancement of wear and corrosion resistance of beta titanium alloy by laser gas alloying with nitrogen[J]. Applied Surface Science, 2016, 367: 80 ? 90.
[32]SANTOS E C, MORITA M, SHIOMI M, et al. Laser gas nitriding of pure titanium using CW and pulsed Nd: YAG lasers[J]. Surface and Coatings Technology, 2006, 201: 1635 ? 1642.
[33]鄒潔, 陳潔, 胡濱. TiN 涂層對牙科鈷鉻合金抗菌腐蝕性能 的影響 [J]. 上海口腔醫學, 2010, 19(2): 173 ? 177.
ZOU Jie, CHEN Jie, HU Bin. Effect of titanium nitride coating on bacterial corrosion resistance of dental Co-Cr alloy[J]. Shanghai Journal of Stomatology, 2010, 19(2): 173 ? 177.
[34] DONAGHY C L, MCFADDEN R, KELAINI S, et al. Creating an antibacterial surface on beta TNZT alloys for hip implant applications by laser nitriding[J]. Optics & Laser Technology, 2020, 121: 105793.
[35]肖憶楠, 喬巖欣, 李月明, 等. 醫用鈦及鈦合金表面改性技 術的研究進展 [J]. 材料導報, 2019, 33(Z2): 336 ? 342.
XIAO Yinan, QIAO Yanxin, LI Yueming, et al. Research development of surface modification technology of biomedical titanium and titanium alloy[J]. Materials Reports, 2019, 33(Z2): 336 ? 342.
[36]FATHI-HAFSHEJANI P, JOHNSON H, AHMADI Z, et al. Phase-selective and localized TiO2 coating on additive and wrought titanium by a direct laser surface modification approach[J]. ACS Omega, 2020, 5(27): 16744 ? 16751.
[37]PARMAR V, KUMAR A, SANKAR M M, et al. Oxidation facilitated antimicrobial ability of laser micro-textured titanium alloy against gram-positive Staphylococcus aureus for biomedical applications[J]. Journal of Laser Applications, 2018, 30(3): 032001.
[38]
CUNHA A, ELIE A M, PLAWINSKI L, et al. Femtosecond laser surface texturing of titanium as a method to reduce the adhesion of Staphylococcus aureus and biofilm formation[J]. Applied Surface Science, 2016, 360: 485 ? 493.
[39]VARIOLA F, YI J H, RICHERT L, et al. Tailoring the surface properties of Ti6Al4V by controlled chemical oxidation[J]. Biomater, 2008, 29(10): 1285 ? 1298.
[40]李華晨, 周廣濤, 陳梅峰, 等. 分步氣體介質下低功率激光 焊接薄板紫銅成形及組織和性能 [J]. 焊接學報, 2020, 41(10): 65 ? 72.
LI Huachen, ZHOU Guangtao, CHEN Meifeng, et al. Research on laser welding formability and microstructure property of copper in stepwise gas medium[J]. Transactions of the China Welding Institution, 2020, 41(10): 65 ? 72.
[41]GALLARDO-MORENO A M, PACHA-OLIVENZA M A, SALDA?A L, et al. In vitro biocompatibility and bacterial adhesion of physico-chemically modified Ti6Al4V surface by means of UV irradiation[J]. Acta Biomaterialia, 2009, 5(1): 181 ? 192.
[42]MITIK-DINEVA N, WANG J, TRUONG V K, et al. Escherichia coli, Pseudomonas aeruginosa, and Staphylococcus aureus attachment patterns on glass surfaces with nanoscale roughness[J]. Current Microbiology, 2009, 58: 268 ? 273.
[43] JEYACHANDRAN Y L, NARAYANDASS S K. The effect of thickness of titanium nitride coatings on bacterial adhesion[J]. Trends in Biomaterials and Artificial Organs, 2010, 24(2): 90 ? 93.
[44] GIRALDEZ M J, RESUA C G, LIRA M, et al. ContactLens hydrophobicity and roughness effects on bacterial adhesion[J]. Optometry and Vision Science, 2010, 87(6): E426 ? E431.
[45]POGODIN S, HASAN J, BAULIN V A, et al. Biophysical model of bacterial cell interactions with nanopatterned cicada wing surfaces[J]. Biophysical Journal, 2013, 104(4): 835 ? 840.
[46]TRUONG V K, LAPOVOK R, ESTRIN Y S, et al. The influence of nano-scale surface roughness on bacterial adhesion to ultrafine-grained titanium[J]. Biomaterials, 2010, 31(13): 3674 ? 3683.
[47]BRAEM A, VAN MELLAERT L, MATTHEYS T, et al. Staphylococcal biofilm growth on smooth and porous titanium coatings for biomedical applications[J]. Journal of Biomedical Materials Research Part A, 2014, 102: 215 ? 224.
[48]司銀芳, 胡語婕, 張凡, 等. 生物合成氧化鋅納米顆粒材料 及其抗菌應用 [J]. 化工進展, 2023, 42(4): 2013 ? 2023.
SI Yinfang, HU Yujie, ZHANG Fan, et al. Biosynthesis of zinc oxide nanoparticles and its application to antibacterial[J]. Chemical Industry and Engineering Progress, 2023, 42(4): 2013 ? 2023.
[49]許晴. 生物活性陶瓷復合材料制備及其抗菌和再生修復 研究 [D]. 北京: 中國科學院大學, 2021.
XU Qing. Preparation of bioactive ceramic composites and its antibacterial activity and regenerative repair effect[D]. Beijing, China: University of Chinese Academy of Sciences, 2021.
[50]ZHOU Yazhou, YANG Juan, HE Tingting, et al. Highly stable and dispersive silver nanoparticle-graphene composites by a simple and low-energy-consuming approach and their antimicrobial activity[J]. Small, 2013, 9(20): 3445 ? 3454.
[51]SHI Anqi, ZHU Chenshun, FU Shan, et al. What controls the antibacterial activity of Ti-Ag alloy, Ag ion or Ti2Ag particles?[J]. Materials Science and Engineering: C, 2020, 109: 110548.
[52]CHEN Mian, YANG Lei, ZHANG Lan, et al. Effect of nano/micro-Ag compound particles on the bio-corrosion, antibacterial properties and cell biocompatibility of Ti-Ag alloys[J]. Materials Science and Engineering: C, 2017, 75: 906 ? 917.
[53]XUE Xianda, LU Libin, HE Donglei, et al. Antibacterial properties and cytocompatibility of Ti-20Zr-10Nb-4Ta alloy surface with Ag microparticles by laser treatment[J]. Surface and Coatings Technology, 2021, 425: 27716.
[54] ZHANG Yanzhe, LIU Xiangmei, LI Zhaoyang, et al. Nano Ag/ZnO-incorporated hydroxyapatite composite coatings: highly effective infection prevention and excellent osteointegration[J]. ACS Applied Materials & Interfaces, 2018, 10(1): 1266 ? 1277.
[55]丁婷婷. 含銀納米材料的制備、抗菌性能及細胞毒性研 究 [D]. 長沙: 湖南大學, 2020.
DING Tingting. Preparation, antibacterial properties and cytotoxicity of silver-containing nanomaterials[D]. Changsha, China: Hunan University, 2020.
[56]MAHARUBIN S, HU Y B, SOORIYAARACHCHI D. Laser engineered net shaping of antimicrobial and biocompatible titanium-silver alloys[J]. Materials Science and Engineering: C, 2019, 105: 110059.
[57]李波. 基于銀基納米復合生物材料靶向協同抗菌用于骨 感染治療 [D]. 上海: 東華大學, 2022.
LI Bo. Targeted synergistic antibacterial based on silverbased nanocomposite biomaterials for bone infection treatment[D]. Shanghai, China: Donghua University, 2022.
[58]SHI Pengyan, SUN Haoliang, ZHANG Haoge, et al. Highly effective antibacterial properties of self-formed Ag nanoparticles/Zr-Ag granular films[J]. Applied Surface Science, 2023, 622: 156929.
[59]ABBASZADEGAN A, GHAHRAMANI Y, GHOLAMI A, et al. The effect of charge at the surface of silver nanoparticles on antimicrobial activity against gram-positive and gram-negative bacteria: A preliminary study[J]. Journal of Nanomaterials, 2015, 2015: 720654.
[60]RAFFI M, HUSSAIN F, BHATTI T M, et al. Antibacterial characterization of silver nanoparticles against E. coli ATCC15224[J]. Journal of Materials Science & Technology, 2008, 24(2): 192 ? 196.
[61]張俊敏. Ti-Ta-Ag 合金的放電等離子體燒結合成機理及 其性能研究 [D]. 昆明: 昆明理工大學, 2022.
ZHANG Junmin. Study on the synthesis mechanism and properties of Ti-Ta-Ag alloy by spark plasma sintering[D]. Kunming, China: Kunming University of Science and Technology, 2022.
[62]KIM S, LEE H S, RYU D, et al. Antibacterial activity of silver-nanoparticles against Staphylococcus aureus and Escherichia coli[J]. Korean Journal of Microbiology & Biotechnology, 2011, 39(1): 77 ? 85.
[63]FENG Q L, WU J, CHEN G Q, et al. A mechanistic study of the antibacterial effect of silver ions on Escherichia coli and Staphylococcus aureus[J]. Journal of Biomedical Materials Research, 2000, 52(4): 662 ? 668.
[64]
羅娟. 納米 Ag-Cu 基抗菌材料的制備及其性能研究 [D].昆明: 昆明理工大學, 2022.
LUO Juan. Preparation and properties of nano Ag-Cu based antibacterial materials[D]. Kunming, China: Kunming University of Science and Technology, 2022.
[65]SRIKANT P, REDDY C K, RAM N R. Metallic particulates for preparation of anti-bacterial preservation vassals and their applications-A review[J]. Materials Today: Proceedings, 2019, 18: 440 ? 444.
[66]ZHANG Erlin, FU Shan, WANG Ruoxian, et al. Role of Cu element in biomedical metal alloy design[J]. Rare Metals, 2019, 38(6): 476 ? 494.
[67]ZHANG Erlin, LI Shengyi, REN Jing, et al. Effect of extrusion processing on the microstructure, mechanical properties, biocorrosion properties and antibacterial properties of Ti-Cu sintered alloys[J]. Materials Science and Engineering: C, 2016, 69: 760 ? 768.
[68]LIU Jie, LI Fangbing, LIU Cong, et al. Effect of Cu content on the antibacterial activity of titanium-copper sintered alloys[J]. Materials Science and Engineering: C, 2014, 35: 392 ? 400.
[69]FOWLER L, JANSON O, ENGQVIST H, et al. Antibacterial investigation of titanium-copper alloys using luminescent Staphylococcus epidermidis in a direct contact test[J].Materials Science and Engineering: C, 2019, 97: 707 ? 714.
[70]BAO Mianmian, LIU Ying, WANG Xiaoyan, et al. Optimization of mechanical properties, biocorrosion properties and antibacterial properties of wrought Ti-3Cu alloy by heat treatment[J]. Bioactive Materials, 2018, 3(1): 28 ? 38.
[71]ZHANG Erlin, REN Jing, LI Shengyi, et al. Optimization of mechanical properties, biocorrosion properties and antibacterial properties of as-cast Ti-Cu alloys[J].Biomedical Materials, 2016, 11: 065001.
[72]JI Hairui, ZHAO Mingchun, XIE Bin, et al. Corrosion and antibacterial performance of novel selective-laser-melted (SLMed) Ti-xCu biomedical alloys[J]. Journal of Alloys and Compounds, 2021, 8644: 158415.
[73]PENG Cong, ZHANG Shuyuan, SUN Ziqing, et al. Effect of annealing temperature on mechanical and antibacterial properties of Cu-bearing titanium alloy and its preliminary study of antibacterial mechanism[J]. Materials Science andEngineering: C, 2018, 93: 495 ? 504.
[74]HOU Baoping, YANG Zhao, YANG Yuling, et al. In vitro bioactivity, tribological property, and antibacterial ability of Ca-Si-based coatings doped with cu particles in-situ fabricated by laser cladding[J]. Applied Physics A, 2018, 124: 256.
[75]LIU Hui, SHI Lizhen, LIU Huan, et al. Corrosion behavior of laser powder bed fusion prepared antibacterial Cu-bearing titanium alloy[J]. Materials Letters, 2023, 331: 133496.
[76]KASCHEL F R, KEAVENEY S, DOWLING D P. Comparison between continuous and modulated wave laser emission modes for the selective laser melting of Ti-6Al-4V: Dimensional accuracy, microstructure and mechanical behaviour[J]. Additive Manufacturing, 2022, 55: 102825.
[77]謝發勤, 何鵬, 吳向清, 等. 鈦合金表面激光熔覆技術的研 究及展望 [J]. 稀有金屬材料與工程, 2022, 51(4): 1514 ? 1524.
XIE Fanqin, HE Peng, WU Xiangqing, et al. Research and prospect of laser cladding technology on titanium alloy surface[J]. Rare Metal Materials and Engineering, 2022, 51(4): 1514 ? 1524.
[78]黃湘湘. 碳鋼表面激光熔覆鋁青銅合金組織和性能研究[D]. 上海: 上海交通大學, 2019.
HUANG Xiangxiang. Microstructure and properties of laser cladded aluminum bronze coating on carbon steel[D]. Shanghai, China: Shanghai Jiao Tong University, 2019.
[79]王亞迪. 基于陽離子-π 作用的銅復合物的抗菌性能與機 理研究 [D]. 北京: 中國科學院大學, 2020. WANG Yadi. Copper complexes based on cation-π interaction: Preparation characterization and antimicrobial activities[D]. Beijing, China: University of Chinese Academy of Sciences, 2020.
第一作者: 馬振,博士,副教授;主要從事醫用鈦合金表面 改性的科研和教學工作;已發表論文 20 余篇;jmsdxmz@163.com。通信作者: 牟立婷,博士,副教授;主要從事醫用生物材料 研究;muliting@163.com。
相關鏈接